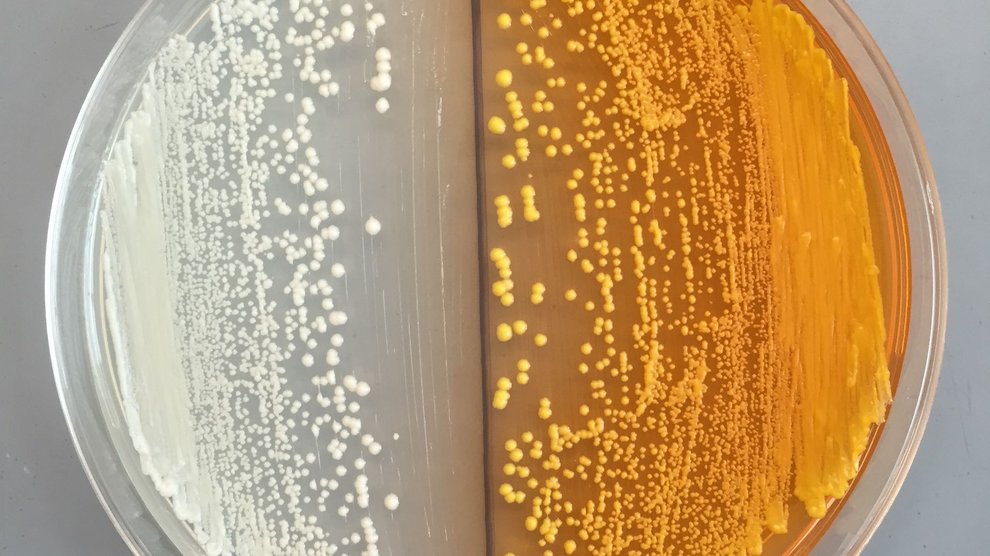

Over just six months, biochemists in John Dueber’s lab at the University of California, Berkeley had completed most of the hard work. With a few tweaks, the yeast they had been cultivating began cranking out not alcohol, but a precursor to morphine.
It’s a breakthrough that experts have been expecting. Scientists have refined the other necessary steps over the last seven years. The last remaining one—which is actually the first step in the process of converting glucose to morphine—was published today in Nature Chemical Biology. It opens the door to yeast-derived opiates and raises concerns that they could flood the illegal drug market. But the modified cells could also lead to the development of more effective and less addictive pain killers.
Yeast is a particularly attractive organism to biochemists. Its genome is well-mapped, and it reproduces rapidly, doubling every couple of hours. We already use them on an industrial scale to mass produce at least one compound—alcohol—and coaxing them to turn out other molecules is only a matter of inserting the right genes in the right places.
Pain killers are one potential target, in part because traditional opiates derived from poppies are highly addictive, and efforts to limit their addictiveness haven’t been very successful. Bespoke yeast cells could make just about any molecule imaginable, including a better opiate.
It could also making producing heroin and other favorites of the drug trade even easier, but home brew heroin isn’t likely to hit the market soon. Here’s Lexi Pandell, reporting for Wired:
“Right now, you would need a background in synthetic biology and genetics to overcome the challenges to produce the right kind of yeast,” says John Dueber, a bioengineer at UC Berkeley and lead author on the study. “It is not an imminent threat. But if a strain made for licit purposes got out, then all that would be required is knowledge of brewing beer to ferment it into morphine.”
Still, the possibility exists, and that has some political scientists and ethicists calling for strict oversight of the genes and techniques used to create opiate-producing yeast. So far, no one has gone from glucose to morphine in one experiment, but with all the necessary methods developed, it probably won’t be long before it happens.



